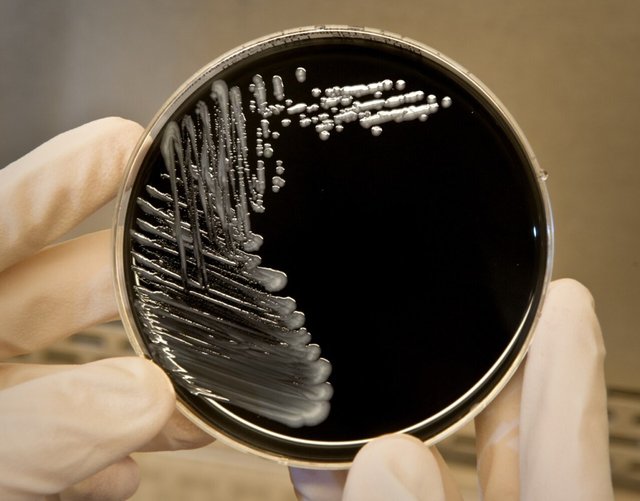

Maine health officials looking for links in 6 cases of Legionnaire's disease - Press Herald
Maine health officials looking for links in 6 cases of Legionnaire's disease - Press Herald
Summary
The CDC is trying to determine whether there are any connections between the cases in the Bangor area, including one in which the patient died.
My Thoughts
The headline and thumbnail of this one speak for itself! Another great article from Pressherald. I suggest checking out the source if you want to learn more.
Thank you for Reading!
This has been your health news update. Thank you so much for reading. I do my best to bring Steem the most up to date news. Please don't forget to leave your thoughts and comments below.
Warning! This user is on my black list, likely as a known plagiarist, spammer or ID thief. Please be cautious with this post!
If you believe this is an error, please chat with us in the #cheetah-appeals channel in our discord.